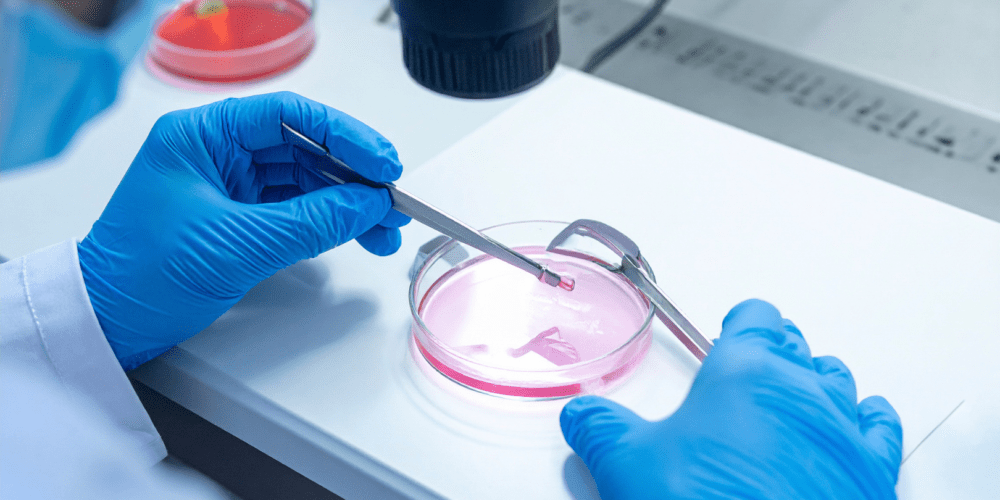

What Tests Are Included in a Fertility Assessment?
Fertility testing is not just one test.
It is a combination of blood tests, hormone analysis, and reproductive assessments. Each test provides a different piece of the puzzle.
Together, they give a complete understanding of fertility.
Female Fertility Tests Explained
Female fertility is mainly assessed through hormone levels and ovarian reserve.
Hormone Blood Tests
These are essential for understanding how the body regulates reproduction.
Key hormones include:
- FSH (Follicle-Stimulating Hormone) – supports egg development
- LH (Luteinising Hormone) – triggers ovulation
- Oestrogen – regulates the menstrual cycle
- Progesterone – confirms ovulation
Imbalances can affect ovulation and timing.

AMH (Anti-Müllerian Hormone)
AMH measures ovarian reserve.
It helps estimate how many eggs remain.
- Higher AMH → higher egg reserve
- Lower AMH → reduced reserve
This is one of the most important fertility markers.
Thyroid Function Testing
Thyroid health plays a key role in fertility.
Abnormal thyroid levels can:
- Disrupt ovulation
- Affect hormone balance
- Increase miscarriage risk
This test is often overlooked but essential.
Male Fertility Tests Explained
Male fertility is assessed through sperm health and hormones.
Semen Analysis
This is the most important test for men.
It evaluates:
- Sperm count
- Motility (movement)
- Morphology (shape)
- Volume
Even small changes can affect fertility outcomes.
Male Hormone Testing
Hormones control sperm production.
Key tests include:
- Testosterone
- FSH
- LH
- Prolactin
Hormonal imbalance can reduce sperm quality.
Advanced Sperm Testing (Optional)
In some cases, deeper testing is needed.
This may include:
- DNA fragmentation testing
- Oxidative stress analysis
These help explain unexplained infertility.
Do You Need All These Tests?
Not always individually. However, combining tests provides better insight.
Testing only one factor can miss underlying issues.
This is why a structured assessment is recommended.
Why a Combined Fertility Assessment Works Best
A full assessment combines:
- Female hormone testing
- Male fertility testing
- Overall health markers
This approach avoids delays and repeated testing.
🔗 Explore full testing here:
https://www.marylebonediagnosticcentre.com/couples-fertility-assessment/How Long Do Fertility Test Results Take?
At Marylebone Diagnostic Centre:
- Most results are ready within 24–42 hours
- Fast turnaround allows quicker decisions
Speed is critical when planning fertility.
How Accurate Are Fertility Tests?
Accuracy depends on laboratory quality.
At MDC:
- Tests are performed under strict protocols
- Results meet the Marylebone High Standard
- External quality assurance is followed
You receive reliable and clinically useful results.
Why Choose Marylebone Diagnostic Centre?
- Central London location
- Fast results within 24–42 hours
- Private and discreet environment
- Comprehensive fertility testing
We provide clarity, not confusion.
Book Your Fertility Assessment
Understanding your fertility starts with the right tests.
Book your Couples Fertility Assessment here:
https://www.marylebonediagnosticcentre.com/couples-fertility-assessment/
The main fertility tests include hormone blood tests, AMH testing, and semen analysis to assess reproductive health.
AMH measures ovarian reserve and helps estimate how many eggs remain, making it a key fertility indicator.
Semen analysis is essential, but hormone testing and advanced tests may also be needed for a full assessment.
Most results are available within 24–42 hours depending on the tests performed.






